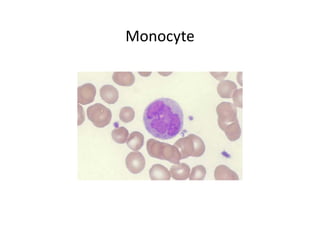
Monocyte

1. Leucocytes are classified as granulocytes (neutrophils, eosinophils, basophils) or agranulocytes (lymphocytes, monocytes).
2. Neutrophils are the most abundant white blood cell and function to phagocytose bacteria and destroy them. They contain granules with antimicrobial proteins.
3. Eosinophils function to deal with parasites and allergies by releasing toxic proteins from their granules that are damaging to parasites.